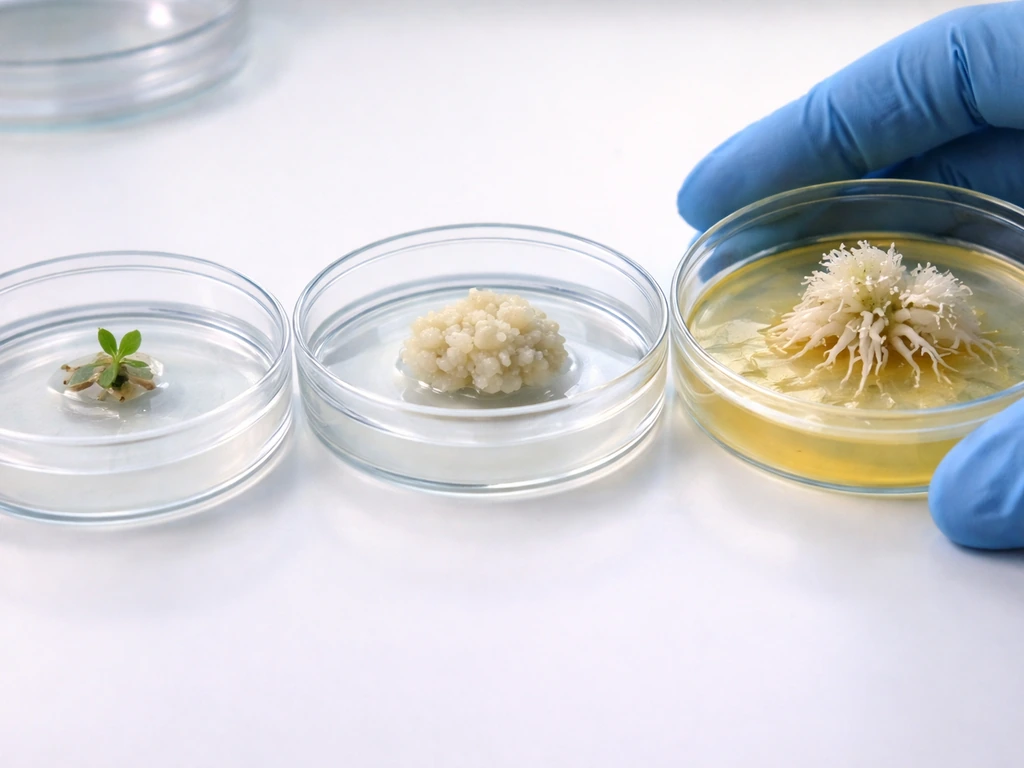
Three sterile Petri dishes showing explant, callus formation, and rooting-stage tissue culture on agar.

Yes, shoot cells can be reprogrammed to form root cells, but it takes the right signals, the right hormone balance, and a cellular reset that doesn't happen by accident. The short version: shoot-derived cells can be coaxed into a root fate by manipulating auxin and cytokinin levels, triggering a process of dedifferentiation (wiping the cell's current identity) followed by re-differentiation into root tissue. This happens in nature during adventitious rooting, and it's something people reproduce deliberately in tissue culture labs and propagation settings every day. Here's exactly how it works.
How Can Root Cells Grow From Shoot Cells: Signals and Steps
Shoot cells vs root cells: why identity isn't permanent

Every cell in a plant carries the same DNA. So why does a leaf cell look and behave nothing like a root cell? The answer is gene expression: different sets of genes are switched on in different tissues, and those expression patterns are locked in by epigenetic marks, meaning chemical modifications to the DNA and its packaging proteins that make certain genes more or less accessible. This is why cell fate is normally stable. Changing it requires actively remodeling those epigenetic states, which is energetically costly and requires specific molecular signals.
Shoot cells are defined partly by the WUS-CLV3 signaling loop at the shoot apical meristem (SAM). WUSCHEL (WUS) maintains stem cells at the shoot tip, while CLV3 acts as a brake to prevent unlimited expansion of that stem cell pool. Root cells, on the other hand, are defined by a different set of master regulators centered on WOX5 (which functions like WUS but in the root's quiescent center), along with PLETHORA (PLT1 and PLT2) transcription factors that pattern the root meristem and maintain stem cell identity there. These are distinct regulatory programs, and under normal development, they stay in their lanes.
Understanding why roots grow downward and shoots grow upwards gives you a sense of just how fundamentally different these tissue types are, not just molecularly, but physically and functionally. A shoot cell and a root cell are running completely different developmental software, even though they share the same hardware.
What signals can override shoot identity and start the root program
The key override signal is auxin, specifically a localized accumulation of auxin that reaches a threshold high enough to activate root-fate regulators. But it's not just "more auxin" in a general sense. The spatial pattern matters. Auxin has to be redirected to specific founder cells via PIN1-mediated polar transport, establishing what researchers call an auxin maximum at a localized site. That maximum is what defines where a new root meristem will form.
On top of auxin, wounding plays a surprisingly important role. When a stem cutting is made, wound signals trigger changes in PIN expression and auxin redistribution at the cut site. Auxin receptors TIR1 and AFBs are involved in translating that signal into a developmental response. In Arabidopsis, wounded tissues can reprogram pericycle-like cells near the wound site into adventitious roots, driven by endogenous auxin including IBA-derived forms. Wound-induced root formation is essentially the plant's version of a reset button.
CLE peptides, a family of small secreted signaling molecules, also regulate meristem-related processes and root meristem differentiation. CLE40, for example, acts in the distal root meristem to regulate WOX5 expression, connecting peptide signaling cues to the WUS/WOX network. These peptide signals help partition developmental fate decisions and can act as checks on whether a root meristem program should be maintained or switched off.
The cellular path: dedifferentiation, reprogramming, and meristem rebuilding

Think of this as a three-stage process. First, the existing cell identity has to be erased or at least loosened. This is dedifferentiation, where the cell loses its specialized characteristics and re-enters a more flexible, pluripotent state, often forming what's called callus (a loosely organized mass of dividing cells). Second, the callus cells get reprogrammed by incoming signals toward a specific fate. Third, that reprogrammed population organizes itself into a meristem, the self-renewing cell hub from which all new root tissue grows.
During regeneration, root-meristem regulators like WOX5, PLT1, and PLT2 are ectopically activated in callus tissue. This isn't a remnant of root identity; these cells were shoot-derived. The activation of these regulators is a genuine reprogramming event. WOX11 is particularly interesting here: it acts as an early step in de novo root organogenesis from leaf tissue, activating WOX5 downstream. So the transcriptional cascade goes WOX11 first, then WOX5, and together they begin rebuilding root stem-cell identity from scratch.
The rebuild of the quiescent center (QC), the slow-cycling cell cluster at the heart of the root stem-cell niche, is the critical endpoint. WOX5 expression has to become confined to those newly formed QC cells, and this confinement depends on correct auxin transport patterning and proper PLT/SCR/auxin cue integration. If those signals don't arrive in the right spatial arrangement, the QC doesn't form correctly, and root meristem maintenance fails. This is one of the most common reasons rooting attempts don't work, as we'll come back to.
The hormone logic: auxin vs cytokinin and why the ratio is everything
If you take one thing from this article, let it be this: root formation is driven by a high auxin-to-cytokinin ratio, while shoot formation is driven by a high cytokinin-to-auxin ratio. This is the Skoog and Miller framework, developed in the 1950s and still the foundational logic of modern tissue culture. It's not about the absolute amount of either hormone; it's about their relative concentrations and how each biases the cell fate decision.
Mechanistically, cytokinin promotes differentiation at the root meristem/elongation boundary by repressing both auxin transport and auxin signaling responses. When cytokinin is high, it actively suppresses root programs. Root-specific markers like WOX5 and PLT2 become undetectable within roughly 48 hours of transferring cells to high-cytokinin media. The antagonism is real, measurable, and fast. Flip the ratio in the other direction, and root identity programs get the chance to activate.
Auxin also feeds back on its own transport machinery. PLT1 and PLT2 promote PIN expression, which increases auxin flux into the root meristem, which in turn stabilizes PLT activity. This positive feedback loop means that once rooting gets started, it can reinforce itself, but it also means that getting started requires crossing a threshold. You need enough auxin, spatially organized correctly, to break the inertia of the existing shoot-identity state.
It's also worth noting that auxin doesn't work alone. Auxin's interactions with other hormones, including ethylene, gibberellin, and strigolactones, all modulate the final outcome. But auxin/cytokinin balance is the dominant variable in most practical rooting contexts.
Practical approaches: tissue culture, cuttings, and grafting
Tissue culture organogenesis
The standard tissue culture workflow for inducing root cells from shoot-derived tissue follows a two-step hormone logic. First, you transfer explant tissue to a callus induction medium with balanced or slightly auxin-heavy hormone concentrations, which breaks down differentiated cell identity and generates a pluripotent callus. Second, you transfer that callus to a root induction medium (RIM) that is rich in auxin and low in cytokinin. This second transfer activates the WOX5/PLT program and begins organogenesis toward a root fate.
In Arabidopsis research, WOX5 and PLT2 signals appear in spatially localized regions of the callus after transfer to auxin-rich RIM, consistent with the sequential staging of root primordium initiation followed by downstream meristem regulator expression. In practical terms, for species like jujube and papaya, hormone concentrations for rooting induction typically fall in the range of 0.5 to 3.0 mg/L for auxins such as NAA or IBA, adjusted based on species, explant type, and age. Cytokinin concentrations (BAP, kinetin, TDZ) are kept low or excluded entirely during the rooting phase.
Think of it like setting a thermostat. During callus induction, you're keeping conditions neutral enough that cells don't commit to either shoot or root fate. During root induction, you're turning the auxin dial up and the cytokinin dial down, giving the cells a clear directional signal.
Adventitious rooting from cuttings
Stem cuttings are the most accessible version of this process. When you take a cutting and dip it in rooting powder (which contains IBA or NAA), you're exploiting wound-induced auxin redistribution plus an external auxin boost. The wounding at the cut base triggers PIN expression changes, and the exogenous auxin establishes the concentration gradient needed to drive founder-cell specification toward root fate. Cuttings from younger, more actively growing shoots tend to work better because those cells retain more competence for reprogramming.
Grafting and tissue interaction
Grafting is a fascinating case where shoot and root tissues are physically joined and have to reorganize across the junction. Auxin and cytokinin levels peak around the graft interface, with auxin levels rising above and cytokinin changes below. In tomato grafts, these hormone maxima appear at roughly 12 hours after grafting. PIN1 and other auxin transporters are upregulated in the scion tissue to push auxin across the junction, and this hormone redistribution is part of what drives tissue reorganization at the interface. Shoots grow in the opposite direction to which force is a good reminder that shoot and root tissues have opposing tropisms to begin with, which makes the coordination at a graft junction all the more impressive biologically.
Comparing the main approaches
| Approach | How rooting is induced | Hormone logic | Best for | Practical difficulty |
|---|---|---|---|---|
| Tissue culture (indirect) | Callus induction then transfer to auxin-rich RIM | High auxin/low cytokinin in root phase | Research, rare/difficult species, micropropagation | High: requires sterile technique, species-specific protocols |
| Tissue culture (direct) | Leaf/shoot explant on auxin medium without callus stage | Auxin-driven with wound signals | Faster organogenesis in responsive species | Medium-high: competence window is narrow |
| Stem cuttings with rooting hormone | Wound + exogenous IBA/NAA at cut base | Auxin boost via rooting powder or gel | Home growers, commercial propagation | Low: accessible but species-dependent success |
| Grafting | Hormone redistribution at graft junction | Auxin/cytokinin peaks drive interface reorganization | Combining rootstocks/scions, disease resistance | Medium: requires technique and compatible species |
For most practical growers, stem cuttings with IBA-based rooting hormone are the right starting point. Tissue culture is worth exploring when you're working with species that root poorly from cuttings, or when you need large numbers of genetically identical plants quickly.
Why rooting fails and what to do about it

Most rooting failures come down to one of five problems, and understanding which one you're dealing with helps you fix it.
- Wrong hormone ratio: The most common issue in tissue culture is using too much cytokinin relative to auxin during the rooting phase, or failing to switch from the callus induction medium to a proper root induction medium. High cytokinin actively suppresses WOX5 and PLT expression within days.
- Incompetent tissue: Older explants lose their ability to be reprogrammed, a real biological constraint. Cells in mature, fully differentiated shoot tissue have more stable epigenetic states that are harder to erase. Use younger, actively growing tissue where possible.
- Failure to establish an auxin maximum: Even with adequate auxin present, rooting fails if auxin transport is disrupted and the required auxin concentration gradient can't form at a specific site. Impaired PIN1 activity or missing auxin transport machinery means the spatial pattern needed to define QC position never materializes.
- Failed meristem maintenance: Even if a root primordium initiates, it can abort if WOX5 expression doesn't get properly confined to the newly formed quiescent center. This requires SCR/PLT/auxin cue integration that can break down if the explant's internal signaling environment is inconsistent.
- Contamination in tissue culture: Bacteria and fungi outcompete plant tissue before reprogramming can complete. Strict sterile technique is non-negotiable, and surface sterilization protocols (typically bleach or ethanol-based) must be calibrated for the specific explant without damaging it.
There's also a broader constraint worth understanding. Just as climbers need support to grow because their structure can't fully self-support, newly initiating root meristems need structural and molecular scaffolding to become self-sustaining. You can't rush the timeline: the stepwise regulatory chronology (WOX11 to WOX5, PLT activation, QC confinement) plays out over hours to days, and skipping conditions that support any of those steps can stall the whole process.
What limits how reliably this works
Cell fate reprogramming is genuinely difficult because it requires reversing epigenetic marks, not just changing which hormones are in the medium. Repressive chromatin modifications, like H3K27me3 marks associated with PRC2 complexes, keep lineage-specific genes silenced, and washing those marks away takes molecular machinery that plant cells don't have in unlimited supply. This is why species that reprogram easily in culture (Arabidopsis, tobacco, some Solanaceae) are treated as model organisms, while others (many woody perennials, monocots) are frustratingly difficult.
The concept of competence is real and measurable. Some tissue is simply more reprogrammable than others, and that competence declines with tissue age, stress history, and genetic background. Mutations in WOX or PLT regulators, or in auxin transport components, can eliminate rooting capacity entirely even under optimal hormone conditions. Understanding where branches grow from gives you a sense of how tightly controlled meristem positioning is in shoots, and the same precision is required when rebuilding a root meristem from scratch.
The practical upshot is that there's no universal protocol. Getting root cells from shoot cells reliably requires knowing your species, using the right hormone concentrations for that system, using competent (typically young and wounded) explant tissue, and being patient enough to let the transcriptional reprogramming cascade play out in sequence. When those conditions are met, the biology is genuinely on your side.
A note on developmental context
It's worth keeping in mind that shoot and root identity aren't arbitrary distinctions. Why the stem grows upwards is rooted (no pun intended) in the same hormonal and gravitational signaling that makes root identity distinct from shoot identity. The developmental programs that separate roots from shoots are ancient and deeply conserved, which is part of why overriding them takes deliberate, well-calibrated intervention.
And finally, remember that meristems are the engine of all plant growth. Whether you're thinking about how new growth can extend from a fixed starting point, or how a single callus cell can eventually form an entire root system, the core principle is the same: cell division, fate specification, and organized patterning driven by molecular signals. Once you see the auxin/cytokinin logic clearly, a lot of what seems mysterious about plant regeneration starts to make very practical sense.
FAQ
If I add enough auxin and keep cytokinin low, why might shoot tissue still not form roots?
Use auxin and cytokinin ratios as your primary dial, but also verify that auxin is being delivered to the correct internal location. If transport is impaired (for example, poor PIN function or damaged vascular connectivity in the explant), cells may experience “wrong placement” of the auxin maximum and fail to form a proper root meristem niche, even when hormone concentrations look correct.
How do I know whether my callus is “good” for root induction versus dead-end tissue?
Callus that is pale, watery, or overly fast-growing often indicates cells are staying in a dedifferentiated but non-committed state. For rooting, you typically want callus that is actively dividing but not massively uncontrolled, then switch promptly to auxin-rich, cytokinin-poor root induction conditions to push the WOX11 to WOX5 cascade.
Does increasing auxin concentration always improve rooting outcomes?
Yes, because auxin maxima formation depends on spatial patterning, not just total hormone. Uniform, overly concentrated auxin can cause stress responses or aberrant tissue organization, leading to callus overgrowth without QC confinement (WOX5 staying diffuse). In practice, growers often adjust both concentration and exposure time rather than only increasing auxin indefinitely.
When should the hormone switch happen from callus induction to root induction?
For many systems, the switch from callus induction to root induction has a window. If you keep cells too long in the neutral or auxin-heavy callus phase, you can accumulate epigenetic and physiological inertia that makes later reprogramming slower or incomplete. If you switch too early, cells may not have formed the right competence state to respond to the root program.
Why do younger shoots and certain explants root better than older or different tissues?
Not necessarily. Leaf and stem tissues differ in baseline competence, endogenous hormone levels, and how easily auxin redistribution occurs after wounding. Younger, actively growing tissue generally has higher reprogramming potential, and wounds that create clear auxin redistribution at the cut base tend to outperform wounds that are superficial or poorly positioned.
Should I use IBA or NAA, and can I substitute one for the other without changing the protocol?
Exogenous auxins like IBA and NAA differ in how strongly and how long they drive downstream signaling once they enter cells. If you switch auxin type, you usually need to re-optimize cytokinin exclusion and the exact auxin dose range, because the internal auxin dynamics and IBA-derived forms can produce different developmental timing and meristem outcomes.
What are common mistakes with media preparation or hormone carryover that stop roots from continuing to develop?
Root meristem maintenance is sensitive to hormone balance over time. If cytokinin contamination or carryover is present in the second medium, root identity regulators such as WOX5/PLT outputs can collapse quickly, which may show up as callus that never transitions into organized primordia or roots that initiate then arrest.
How can I tell whether the problem is “failure to initiate” versus “failure to build/maintain the meristem”?
Look for signs consistent with meristem organization, not just root-like bumps. If WOX5 confinement and QC rebuilding do not occur correctly, you may see disorganized tissue, callus that doesn’t produce stable root primordia, or roots that emerge but fail to elongate and branch. This often traces back to incorrect auxin transport patterning or lingering cytokinin effects.
If hormone ratios are right, what non-hormone factors most often reduce rooting success?
Provide a competent physiological context for the explant. Even with correct hormone ratios, stress, extreme desiccation, or poor oxygenation can change redox state and interfere with dedifferentiation and the timing of re-differentiation. In many workflows, gentle handling and consistent culture conditions improve competence and reduce failure rates.
What if my plant variety basically refuses to root even under optimized auxin media?
When rooting is very poor, it is often due to low competence or a genetic/transport limitation, not simply insufficient auxin. Check whether your genotype has defects in WOX/PLT regulatory capacity or in auxin transport components, because those constraints can eliminate rooting even under optimized media. In those cases, switching explant type, improving wounding strategy, or changing auxin delivery approach may be more effective than further increasing auxin.
Why might the same auxin/cytokinin recipe work one time and fail another?
Do not ignore the timing of endogenous hormone interplay. Ethylene, gibberellins, and strigolactones can modulate the auxin response, so a protocol that works in one cultivar or season may drift in another. If rooting behavior changes unpredictably, re-check the overall physiological state of the donor plant and avoid adding extra stressors that alter ethylene or GA dynamics.
What wounding approach best supports adventitious root formation from shoot cuttings?
For cuttings, the external auxin boost works best when the wound-induced redistribution can establish a localized auxin maximum at the base. Deep, well-positioned cuts that effectively trigger PIN changes generally perform better than tiny or poorly cleaned injuries that do not reliably redirect auxin.
Explain Why Cells Can’t Keep Growing Larger
Discover why cells stop enlarging: surface-area limits, diffusion and metabolism, genome scaling, and mechanics force di

